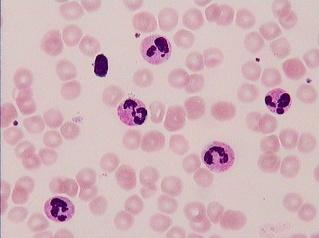
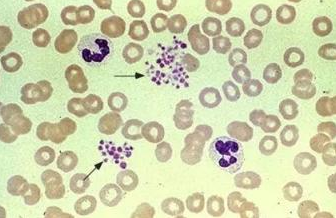

血常规科普——人人都能看懂!
血常规这个检查,可以说几乎每个人都做过,甚至说小孩刚出生就在医院完成了这个检查,在门诊、住院还有体检中都是必做的项目。
血常规的科普文章有很多,但是大多都是长篇论著,把专业知识一字不漏的照抄过来,普通人看不懂,看不下去,不能做到去繁就简,收放自如。因此本人特写此文,尽量简明扼要,易懂易记。
血液中的有形成分是:红细胞、白细胞、血小板。血常规简单的讲就是检查这三个指标的。
显微镜下的红细胞(放大1000倍)

显微镜下的白细胞(放大1000倍):比红细胞大,有核
显微镜下的血小板(放大1000倍):比红细胞小,成堆聚集或散落存在
血常规报告结果分析
1、 红细胞计数与血红蛋白:
诊断有无贫血,初步判断贫血类型。男性血红蛋白<120g/L,女性血红蛋白<110g/L。
2、 白细胞计数与分类:
白细胞升高意味着有炎症感染存在,一般是细菌感染,主要是以中性粒细胞升高为主;白细胞下降,多见于病毒感染,表现为中性粒细胞减少,而淋巴细胞比例相对增高。因此可以用于指导临床用药:抗细菌或抗病毒。
另外白细胞大幅升高,比如大于30 x 10^9/L,需要考虑白血病;白细胞下降也可由化学药物、物理射线导致。
3、 血小板计数:
血小板的功能是止血、参与凝血。血小板计数减少,则意味着止血、凝血功能出现问题了,如血小板减少性紫癜;血小板计数大幅升高,多见于骨髓增生性疾病,如原发性血小板增多症,一般的轻微升高,意义不大,无需担心。

 科普中国APP
科普中国APP 科学素质竞赛
科学素质竞赛 幸福肥东微信
幸福肥东微信 合肥科普微信
合肥科普微信 肥东科协
肥东科协